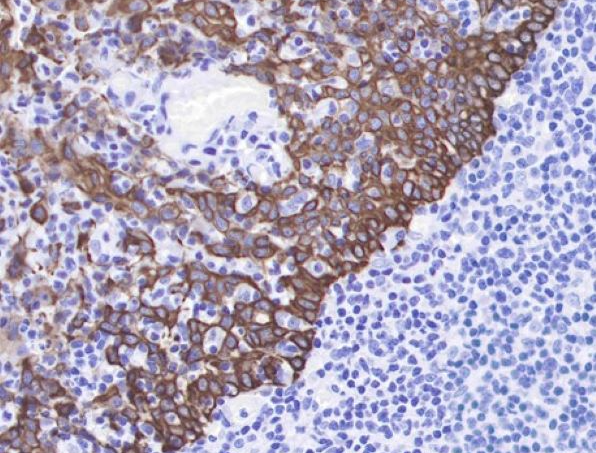
How to Achieve Efficient Optimization of Antibody Affinity?

How to Achieve Efficient Optimization of Antibody Affinity?
Concept
Antibody affinity refers to the intrinsic binding strength between a single antibody variable region and its cognate antigen epitope, quantified by the equilibrium dissociation constant (KD)—a core biophysical parameter that directly dictates antibody performance in therapeutic, diagnostic, and research applications. Efficient antibody affinity optimization is a rational and experimental engineering process that enhances antibody-antigen binding strength (reduces KD value) through targeted amino acid modifications, library screening, and structural design, while balancing critical attributes such as specificity, structural stability, immunogenicity, and developability. Unlike simple affinity enhancement, efficient optimization pursues a synergistic improvement of binding kinetics (faster association rate, slower dissociation rate) and functional suitability, ensuring the optimized antibody exhibits superior in vitro and in vivo performance for its intended application.
Research Frontier
Driven by the integration of structural biology, computational biology, artificial intelligence, and high-throughput screening technology, antibody affinity optimization is evolving rapidly toward intelligent rational design, high-throughput directed evolution, and multi-parameter synergistic optimization. The key cutting-edge trends defining the next generation of affinity optimization technologies are as follows:
- AI-powered predictive affinity maturation: Deep learning and machine learning models trained on massive antibody-antigen structural and sequence datasets predict the impact of single or combinatorial amino acid mutations on binding affinity and kinetics. These models enable targeted design of mutation libraries with high hit rates, eliminating the randomness of traditional screening and drastically improving optimization efficiency.
- Structure-guided precision mutagenesis: High-resolution cryo-EM and X-ray crystallography reveal the atomic-level interaction details of antibody-antigen complexes, identifying hot-spot amino acids and key binding interfaces. Computational tools such as molecular docking and free energy calculation guide the precise modification of these residues to enhance intermolecular interactions (hydrogen bonds, hydrophobic interactions, salt bridges), achieving affinity enhancement with minimal sequence changes.
- Next-generation display system for directed evolution: Advanced in vitro display technologies (mammalian cell display, ribosome display, yeast surface display 2.0) enable the screening of ultra-large mutation libraries (10¹⁰–10¹² clones) with improved folding and post-translational modification of antibodies, yielding high-affinity variants with better in vivo compatibility than traditional phage display.
- Multi-parameter simultaneous optimization: Integrated optimization platforms that couple affinity enhancement with the evaluation of specificity, stability, solubility, immunogenicity, and pharmacokinetics. These platforms use multi-objective screening algorithms to identify antibody variants that achieve optimal affinity while maintaining or improving other critical functional and developability attributes.
- Dynamic and conditional affinity optimization: Novel design strategies that engineer antibodies with environment-responsive affinity—enabling the antibody to exhibit high affinity in target tissues (e.g., tumor microenvironment with low pH or high antigen concentration) and low affinity in normal tissues, reducing off-target effects and improving therapeutic index.
- Automated and miniaturized optimization workflows: Lab-on-a-chip and microfluidic-based high-throughput screening systems that miniaturize experimental scale, reduce reagent consumption, and automate the entire process from mutation library construction to affinity validation. These systems shorten optimization cycles from months to weeks and lower overall development costs.
Research Significance
Antibody affinity optimization is a core technical step in antibody development and engineering, with profound scientific, clinical, and industrial significance for the biopharmaceutical industry, clinical diagnostics, and life science research:
- Elevating the efficacy and safety of therapeutic antibodies: High-affinity therapeutic antibodies bind to target antigens at lower doses, enhancing target engagement and therapeutic efficacy while reducing systemic exposure and off-target toxic side effects. Optimized binding kinetics (slow dissociation) ensures prolonged target occupancy at disease sites, further improving therapeutic outcomes for cancer, autoimmune diseases, and infectious diseases.
- Boosting the sensitivity and accuracy of diagnostic antibodies: High-affinity antibodies enable the detection of ultra-low concentrations of disease biomarkers (e.g., tumor-specific antigens, viral proteins), achieving early disease diagnosis and precise quantitative detection. This is critical for improving the clinical value of in vitro diagnostic (IVD) reagents and enabling personalized medicine.
- Improving the performance of research and imaging antibodies: Higher-affinity antibodies enhance the signal-to-noise ratio in techniques such as immunoprecipitation (IP), chromatin immunoprecipitation (ChIP), immunofluorescence (IF), and in vivo molecular imaging. They enable the reliable detection of low-abundance proteins and accurate visualization of protein localization and interactions, advancing life science research.
- Reducing the development and manufacturing costs of antibody products: High-affinity antibodies require lower doses for clinical application or diagnostic use, reducing the scale of recombinant expression and purification. Additionally, efficient affinity optimization shortens the lead antibody development cycle, reduces screening costs, and improves the success rate of downstream development—lowering the overall cost of antibody product commercialization.
- Enabling the development of novel antibody-based formats: Affinity optimization is a prerequisite for the development of novel antibody formats such as bispecific antibodies, antibody-drug conjugates (ADCs), nanobodies, and antibody fragments. These formats often require high affinity to compensate for their smaller molecular size or reduced valency, making efficient affinity optimization essential for their functional success.
Related Mechanisms and Technical Approaches
Why Antibody Affinity Is a Critical Parameter in Biopharmaceutical R&D
Antibody affinity is the fundamental biophysical property that determines the functional performance of an antibody in all applications, and its importance in biopharmaceutical research and development stems from its direct and profound impact on antibody efficacy, safety, pharmacokinetics, and practical utility. Unlike avidity (the overall binding strength of a multivalent antibody), affinity reflects the intrinsic binding ability of the antibody-antigen pair and is a decisive factor for antibody performance, for the following key reasons:
- Directly impacts therapeutic efficacy and dosage: For therapeutic antibodies, a lower KD value (higher affinity) means the antibody can bind to target antigens at nanomolar or even picomolar concentrations, achieving effective target engagement with lower clinical doses. This not only enhances the therapeutic effect by ensuring sufficient target occupancy but also reduces the risk of adverse reactions caused by high-dose administration.
- Regulates antibody pharmacokinetic and tissue distribution properties: Antibody affinity modulates target-mediated drug disposition (TMDD)—a key process in antibody clearance. Moderately high affinity ensures prolonged target binding and retention in disease tissues, while excessively high affinity may lead to irreversible target binding, rapid clearance of the antibody-antigen complex, and uneven tissue distribution. Rational affinity optimization achieves the optimal balance of TMDD and serum half-life, improving in vivo bioavailability.
- Determines diagnostic sensitivity and detection limits: Diagnostic antibodies rely on high affinity to detect low-abundance biomarkers in complex biological samples (e.g., serum, plasma). High affinity reduces non-specific binding and background noise, enabling the accurate and sensitive detection of early-stage disease biomarkers that are present at extremely low concentrations—an essential requirement for early disease diagnosis and screening.
- Is a prerequisite for maintaining specificity in complex systems: In biological systems with high homology between target and off-target proteins, high affinity combined with high specificity ensures the antibody selectively binds to the target antigen, avoiding cross-reactivity. Affinity optimization that prioritizes specificity prevents off-target effects in therapy and false positive/negative results in diagnosis.
- Supports the functional success of novel antibody formats: Novel antibody formats such as nanobodies, scFv, and bispecific antibodies often have a single binding domain or reduced valency, meaning their overall avidity is dependent on intrinsic affinity. Efficient affinity optimization is therefore critical for ensuring these formats exhibit sufficient binding strength and functional activity in vitro and in vivo.
In summary, antibody affinity is not just a quantitative parameter but a core design element that must be tailored to the intended application. Systematic and efficient affinity optimization is essential for developing high-performance antibody products with superior efficacy, safety, and practical utility.
Main Technical Strategies for Efficient Antibody Affinity Optimization
Efficient antibody affinity optimization combines rational design (driven by structural and computational data) and experimental screening (driven by directed evolution and display technologies) to achieve targeted and high-magnitude affinity enhancement. These strategies are complementary, and the optimal approach is selected based on the availability of antibody-antigen structural data, the desired affinity improvement, and the need to balance other antibody attributes. The main technical strategies are as follows:
- Structure-Guided Rational Design
A hypothesis-driven strategy that uses high-resolution structural data of the antibody-antigen complex (X-ray crystallography, cryo-EM) and computational biology tools to identify key amino acid residues involved in binding (hot spots). Key techniques include:
- Molecular docking and molecular dynamics simulation: Predict the binding mode and intermolecular interactions of the antibody-antigen complex, and simulate the impact of amino acid mutations on binding stability and energy.
- Site-directed mutagenesis: Introduce targeted mutations to hot-spot residues in the complementarity-determining regions (CDRs) or framework regions (FRs) to enhance hydrogen bonding, hydrophobic interactions, or salt bridges between the antibody and antigen.
- Combinatorial mutagenesis: Generate small, focused mutation libraries of key residues to screen for synergistic effects of multiple mutations on affinity.
This strategy is highly efficient with a high hit rate, ideal for cases where structural data is available, and minimizes unintended changes to the antibody sequence.
- In Vitro Display Technology-Based Directed Evolution
A discovery-driven strategy that simulates natural evolution by constructing large-scale antibody mutation libraries and screening for high-affinity variants using in vitro display systems. The most widely used platforms include:
- Phage display: The most mature technology, which fuses antibody fragments (scFv, Fab) to phage coat proteins and displays them on the phage surface. Multiple rounds of panning (binding, washing, elution) enrich phages displaying high-affinity antibodies, with affinity improvements of 10–1000-fold achievable.
- Yeast surface display: Displays full-length antibodies or fragments on the yeast cell surface, enabling quantitative screening of binding affinity and kinetics using flow cytometry. This platform supports the screening of larger libraries and better preserves antibody folding and post-translational modification.
- Mammalian cell display: Displays fully human antibodies with native glycosylation on mammalian cell surfaces, yielding high-affinity variants with superior in vivo compatibility and developability.
This strategy is ideal for cases where structural data is unavailable, and can generate novel antibody variants with unexpected affinity-enhancing mutations.
- Immune Library and Single B-Cell Cloning
A natural discovery strategy that mines high-affinity antibody sequences from natural immune repertoires, leveraging the body’s own immune system to generate affinity-matured antibodies. Key techniques include:
- Immune phage libraries: Construct phage libraries from the B-cells of immunized animals or humans, which contain naturally affinity-matured antibody sequences.
- Single B-cell cloning: Isolate individual antigen-specific B-cells from immunized animals or convalescent patients using flow cytometry, and directly amplify their antibody variable region genes. This technology enables the rapid isolation of naturally occurring high-affinity antibodies with no in vitro screening required.
This strategy yields antibodies with natural affinity maturation and good structural stability, ideal for developing fully human therapeutic antibodies.
- Random Mutagenesis and High-Throughput Screening
A broad-based strategy that introduces random mutations to the antibody CDRs (or entire variable region) using chemical mutagens, error-prone PCR, or DNA shuffling, generating large, diverse mutation libraries. High-throughput screening methods (e.g., ELISA, fluorescence-activated cell sorting (FACS), microfluidics) are used to identify high-affinity variants. This strategy is simple to implement and can generate novel mutations, but has a lower hit rate and requires efficient screening platforms.
How to Evaluate and Validate the Effects of Antibody Affinity Optimization
A comprehensive, multi-dimensional evaluation and validation system is essential to ensure the success of antibody affinity optimization, as it not only quantifies affinity enhancement but also verifies the maintenance of other critical antibody attributes (specificity, stability, functional activity). The evaluation methods combine label-free biophysical techniques (for precise kinetic and thermodynamic parameters) and biological functional assays (for in vitro and in vivo performance validation), with cross-validation across multiple methods to ensure accurate and reliable results. The key evaluation techniques and their applications are as follows:
- Label-Free Biophysical Techniques (Gold Standard for Affinity Measurement)
These techniques measure antibody-antigen binding in real time without labeling, preserving the native conformation of the biomolecules and providing precise kinetic and thermodynamic parameters (KD, ka: association rate, kd: dissociation rate).
- Surface Plasmon Resonance (SPR): The gold standard for antibody affinity and kinetic measurement. It detects changes in refractive index at a sensor surface to monitor antibody-antigen binding in real time, providing high-precision KD values (down to picomolar range) and kinetic parameters. Ideal for quantifying affinity enhancement and optimizing binding kinetics.
- Bio-Layer Interferometry (BLI): A portable, high-throughput alternative to SPR. It measures interference pattern changes of light reflected from a biosensor tip to monitor binding, enabling rapid screening of multiple antibody variants and quantification of affinity. Suitable for primary screening of mutation libraries and batch validation of affinity.
- Isothermal Titration Calorimetry (ITC): Measures the thermodynamic changes (enthalpy, entropy, free energy) during antibody-antigen binding, providing insights into the molecular basis of affinity enhancement (e.g., hydrophobic interactions, hydrogen bonding). Ideal for understanding the mechanism of binding and validating the stability of the antibody-antigen complex.
- Immunoassay-Based Comparative Evaluation
These techniques are simple, high-throughput, and cost-effective, suitable for primary screening of mutation libraries and comparative evaluation of binding strength between antibody variants.
- Enzyme-Linked Immunosorbent Assay (ELISA): A widely used method for qualitative and semi-quantitative evaluation of antibody binding. It measures the absorbance of a reporter enzyme to compare the binding strength of different antibody variants to immobilized antigen, suitable for primary screening of large libraries.
- Fluorescence Polarization (FP): A homogeneous assay that measures the polarization of fluorescence emitted by a labeled antigen upon binding to an antibody. It enables rapid, high-throughput quantification of affinity and is ideal for screening small molecule-antibody or peptide-antibody interactions.
- Cellular and Functional Validation Assays
These assays evaluate antibody binding and functional activity in a physiologically relevant cellular context, verifying that in vitro affinity enhancement translates to improved biological function.
- Flow Cytometry: Evaluates antibody binding to native antigen expressed on the surface of live cells, providing quantitative data on binding efficiency and specificity. Ideal for validating the functional binding of therapeutic antibodies to cell surface targets.
- Neutralization Assays: Measures the ability of the optimized antibody to neutralize the biological activity of the target antigen (e.g., viral neutralization, receptor-ligand inhibition). Directly validates the functional efficacy of therapeutic antibodies and ensures affinity enhancement translates to improved therapeutic activity.
- Immunoprecipitation (IP): Evaluates the ability of the optimized antibody to pull down the target antigen from complex cell lysates, verifying specificity and binding strength in a native biological environment. Ideal for validating research antibodies.
- In Vivo Validation (for Therapeutic and Imaging Antibodies)
For antibodies intended for in vivo applications, in vivo validation is critical to verify that affinity enhancement translates to improved in vivo performance, including target tissue accumulation, retention, and therapeutic efficacy. Techniques include in vivo molecular imaging (PET, fluorescence), pharmacokinetic (PK) studies, and in vivo efficacy studies in animal disease models.
Key Technical Challenges in Antibody Affinity Optimization
Despite significant advancements in optimization technologies, antibody affinity optimization still faces a series of technical and practical challenges that stem from the complex relationship between antibody affinity and other structural, functional, and developability attributes. These challenges require a balanced and integrated approach to optimization, rather than a sole focus on affinity enhancement. The main technical challenges are as follows:
- Trade-off between affinity enhancement and immunogenicity: Affinity maturation through mutagenesis (especially in the CDRs) may introduce novel T-cell/B-cell epitopes in the antibody sequence, increasing the risk of anti-drug antibody (ADA) production in humans. This is a critical challenge for therapeutic antibodies, as ADAs can neutralize antibody activity or cause adverse reactions.
- Loss of specificity with affinity enhancement: In some cases, affinity optimization may increase non-specific binding or cross-reactivity with homologous proteins, as mutations that enhance binding to the target antigen may also create new interactions with off-target proteins. Maintaining high specificity while improving affinity is a key challenge, especially for targets with high homology to other proteins.
- Structural constraints of antigen epitopes: Some antigen epitopes (e.g., linear, shallow, or hydrophobic epitopes) have inherent structural limitations that prevent large-scale affinity enhancement. For these epitopes, traditional mutagenesis strategies may yield only marginal affinity improvements, requiring innovative design approaches (e.g., antibody format engineering, multi-valency).
- Complexity of multivalent antibody affinity optimization: Multivalent antibodies (e.g., bispecific antibodies, IgM) exhibit avidity (synergistic binding of multiple domains), and affinity optimization of individual binding domains must consider their synergistic effects. Unbalanced optimization of individual domains may reduce overall avidity and functional activity, making multivalent antibody optimization far more complex than monovalent antibodies.
- In vitro-in vivo correlation (IVIVC) gaps: Antibodies optimized for high affinity in vitro may exhibit poor in vivo performance due to factors such as altered pharmacokinetics, tissue distribution, or target-mediated clearance. The lack of reliable IVIVC models makes it difficult to predict in vivo performance from in vitro affinity data, requiring extensive in vivo validation.
- Balance between affinity and other developability attributes: Affinity enhancement may inadvertently reduce antibody structural stability, solubility, or expression efficiency, or increase aggregation propensity. These developability issues can make downstream manufacturing and commercialization unfeasible, meaning affinity optimization must be coupled with the evaluation of all critical developability attributes.
- Cost and time efficiency of optimization workflows: Traditional affinity optimization workflows (e.g., large-scale phage display screening) are time-consuming (months) and costly, with low hit rates for high-magnitude affinity enhancement. For small and medium-sized biotech companies, these costs and timeframes can be a significant barrier to development.
ANT BIO PTE. LTD.’s Professional Antibody Affinity Optimization Services
ANT BIO PTE. LTD. leverages its advanced antibody engineering, directed evolution, and structural biology platforms to provide end-to-end, efficient antibody affinity maturation and optimization services for global biopharmaceutical enterprises, diagnostic reagent developers, and life science researchers. Our integrated approach combines structure-guided rational design and high-throughput directed evolution (phage/yeast display) to enhance the binding affinity (KD value), specificity, and functional activity of your existing antibody candidates (scFv, Fab, IgG, nanobodies, bispecific antibodies)—achieving affinity improvements of 10–1000-fold while balancing critical attributes such as stability, solubility, immunogenicity, and developability.
Backed by a team of senior antibody engineers, computational biologists, and protein scientists, we have rich experience in optimizing antibodies for therapeutic, diagnostic, and research applications, with a proven track record of delivering high-performance antibody variants for a wide range of targets (soluble proteins, membrane proteins, peptide antigens, and small molecules). Our one-stop service covers the entire affinity optimization workflow—from antibody sequence analysis and mutation library design to high-throughput screening, recombinant expression, purification, and comprehensive multi-dimensional validation—providing a turnkey solution for antibody affinity enhancement.
Core Service Advantages
Our antibody affinity optimization services stand out in the industry for integrated rational design and experimental screening, multi-parameter balance, end-to-end workflows, and clear, measurable results, with a customer-centric approach to tailor solutions for every project’s unique needs:
|
Core Service Advantages |
Detailed Description |
|
End-to-End Integrated Optimization Workflow |
We provide a complete, turnkey solution from start to finish: antibody sequence/structural analysis → mutation library design (focused/random) and construction → high-throughput screening (phage/yeast display, SPR/BLI) → positive clone sequencing and characterization → recombinant expression (mammalian/prokaryotic) and purification → comprehensive affinity and functional validation (SPR/BLI, flow cytometry, neutralization assays). No third-party collaboration is required, ensuring project efficiency and data consistency. |
|
Synergistic Rational Design + Directed Evolution |
We combine the high hit rate of structure-guided rational design (for projects with structural data) with the discovery power of directed evolution (phage/yeast display) for projects without structural data. This synergistic approach maximizes the magnitude of affinity enhancement (10–1000-fold) and minimizes the risk of unintended sequence changes, yielding optimized antibodies with superior binding kinetics and structural stability. |
|
Balanced Affinity and Critical Biophysical/Functional Attributes |
Unlike single-focus affinity enhancement, we concurrently monitor and evaluate specificity, structural stability (thermal/chemical), solubility, aggregation propensity, and immunogenicity throughout the optimization process. We use multi-objective screening to identify antibody variants that achieve optimal affinity while maintaining or improving other critical attributes, avoiding developability issues in downstream production. |
|
Comprehensive, Gold-Standard Validation |
All optimized antibody variants undergo rigorous validation using gold-standard biophysical and functional assays: SPR/BLI for precise KD/kinetic parameter measurement, flow cytometry for cellular binding validation, neutralization assays for functional efficacy (therapeutic antibodies), and ELISA/IP for research/diagnostic antibody performance. We provide detailed quantitative data on affinity enhancement and functional improvement for full transparency. |
|
Measurable Results and Customizable Deliverables |
Our final deliverables include optimized high-affinity antibody gene sequences, purified recombinant antibody samples (mg to gram scale), and a comprehensive affinity enhancement report with quantitative data (e.g., KD reduction, fold affinity improvement, kinetic parameters). Optional add-on services include antibody humanization, Fc engineering, and in vivo validation, tailored to your project’s downstream needs. |
|
Professional Technical Support and Iterative Optimization |
Our team of antibody engineering experts provides dedicated technical support throughout the project, including data analysis, result interpretation, and iterative optimization. If initial affinity enhancement does not meet your requirements, we conduct additional rounds of mutagenesis and screening at no extra cost (for qualified projects), ensuring the final antibody variant achieves your desired affinity and performance goals. |
Primary Application Scenarios
Our antibody affinity optimization services are tailored to meet the diverse needs of therapeutic, diagnostic, and research antibody development, providing targeted affinity enhancement solutions for every key application scenario:
|
Primary Application Scenarios |
Optimization Goals & Service Value |
|
Therapeutic Antibody Optimization |
Enhance target binding affinity and neutralization activity, reduce clinical dosage, improve in vivo target occupancy and therapeutic efficacy, and minimize off-target toxic side effects. Service Value: Develop high-potential lead therapeutic antibodies with superior in vitro and in vivo performance, accelerating clinical translation. |
|
High-Sensitivity Diagnostic Reagent Development |
Improve antibody affinity to lower the detection limit of disease biomarkers, enhance diagnostic sensitivity and accuracy, and enable early disease detection and quantitative screening. Service Value: Develop high-performance diagnostic antibodies for IVD reagents, increasing their clinical value and market competitiveness. |
|
In Vivo Imaging and Targeted Delivery |
Strengthen antibody binding affinity to enhance target tissue (e.g., tumor) accumulation and retention, improve the signal-to-noise ratio of in vivo molecular imaging (PET/fluorescence), and enhance the delivery efficiency of antibody-drug conjugates (ADCs) and nanoparticle-based drug delivery systems. Service Value: Optimize antibody probes and targeting moieties for precise in vivo imaging and targeted therapy. |
|
Research Antibody Tool Upgrades |
Enhance antibody affinity to improve the signal-to-noise ratio in IP, ChIP, IF, and Western Blot, enable the detection of low-abundance proteins, and improve the reliability and reproducibility of experimental results. Service Value: Provide high-performance research antibodies that advance life science research and reduce experimental variability. |
|
Novel Antibody Format Optimization |
Optimize the affinity of nanobodies, scFv, bispecific antibodies, and other novel formats to compensate for reduced valency or molecular size, ensuring sufficient binding strength and functional activity in vitro and in vivo. Service Value: Unlock the functional potential of novel antibody formats for next-generation therapy and diagnosis. |
We have established a seamless integration of computational design, high-throughput screening, and experimental validation platforms, with the capability to optimize antibodies for all target types and applications. Our services are designed to accelerate your antibody development process, reduce costs, and improve the success rate of downstream commercialization—making us your most trusted partner for antibody affinity optimization and engineering.
Brand Mission
At ANT BIO PTE. LTD., our core mission is to empower life science breakthroughs and drive biopharmaceutical innovation by providing high-quality, innovative, and reliable biological reagents, technical services, and engineering solutions for global researchers and industrial professionals.
Leveraging our advanced platforms in antibody engineering, directed evolution, recombinant protein expression, and structural biology, we are committed to solving the core technical challenges in antibody development and optimization, providing one-stop services for antibody affinity maturation, sequence design, customization, and engineering. Our three specialized sub-brands (Absin, Starter, UA) cover the entire spectrum of life science research and biopharmaceutical development needs—from general reagents and kits to high-performance antibodies and recombinant proteins—providing comprehensive, systematic solutions for basic research, clinical diagnostics, and therapeutic antibody development.
We adhere to the core values of innovation, quality, and customer-centricity, continuously advancing our technologies and services through interdisciplinary integration and research collaboration. We strive to provide the most cutting-edge and reliable solutions for our customers, bridging the gap between technological innovation and industrial application, and contributing to the exploration of life science mysteries, the development of novel antibody drugs, and the improvement of human health.
Related Product & Service List
|
Category |
Product/Service Name |
Key Features & Advantages |
Inquiry |
|
Antibody Affinity Optimization |
Antibody Affinity Maturation (Rational Design) |
Structure-guided, site-directed mutagenesis, high hit rate, minimal sequence changes, SPR/BLI validation |
Available Now |
|
Antibody Affinity Optimization |
Antibody Affinity Maturation (Display Technology) |
Phage/yeast display, large-scale library screening, 10–1000-fold affinity improvement, high-throughput validation |
Available Now |
|
Antibody Affinity Optimization |
Bispecific/Nanobody Affinity Optimization |
Tailored for novel formats, valency balance, functional activity validation, in vivo compatibility |
Available Now |
|
Antibody Engineering |
Antibody Humanization & Fc Engineering |
Coupled with affinity optimization, low immunogenicity, Fc function modulation (half-life/effector activity) |
Available Now |
|
Antibody Validation |
SPR/BLI Affinity & Kinetics Measurement |
Gold-standard KD/ka/kd measurement, high-precision, label-free, real-time binding analysis |
Available Now |
|
Recombinant Antibody Production |
Optimized Antibody Expression & Purification |
Mammalian/prokaryotic expression, high yield, high purity (>95%), endotoxin removal |
Available Now |
AI Disclaimer
This article was partially created with the assistance of artificial intelligence. If any content involves copyright or intellectual property issues, please inform us, and we promise to verify and remove it immediately.
ANT BIO PTE. LTD. – Empowering Scientific Breakthroughs
At ANTBIO, we are committed to advancing life science research through high-quality, reliable reagents and comprehensive solutions. Our specialized sub-brands (Absin, Starter, UA) cover a full spectrum of research needs, from general reagents and kits to antibodies and recombinant proteins. With a focus on innovation, quality, and customer-centricity, we strive to be your trusted partner in unlocking scientific mysteries and driving medical progress. Explore our product portfolio today and elevate your research to new heights.





